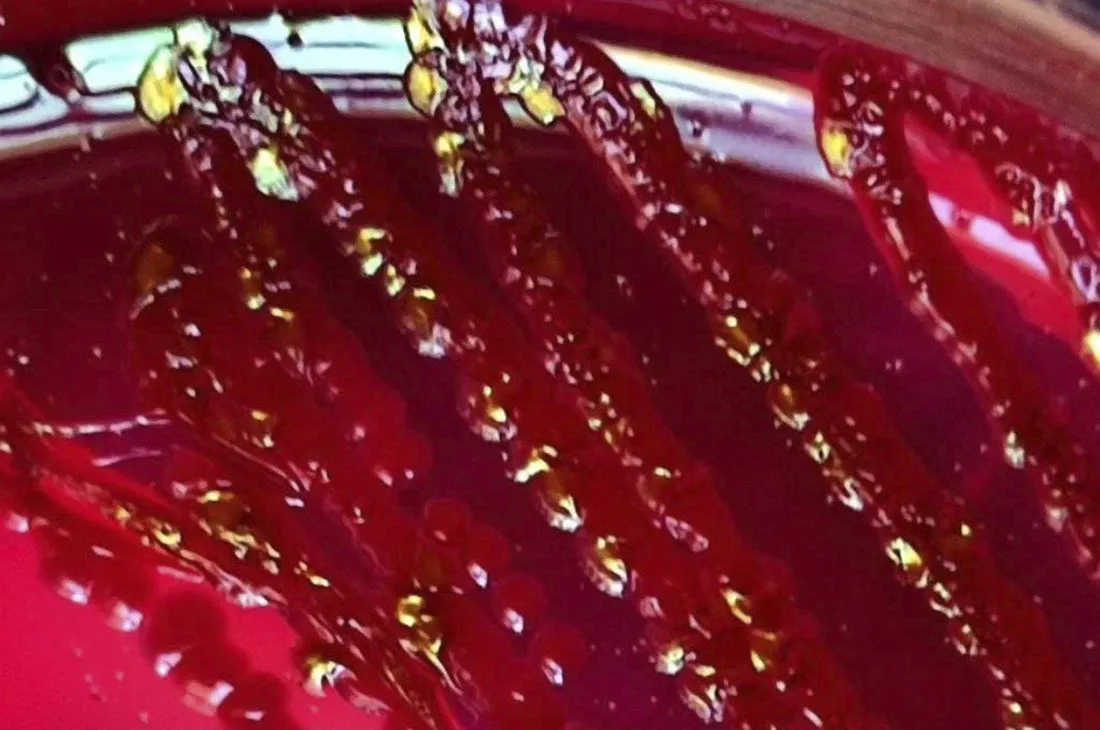

Новости
В белорусских фонтанах обнаружены бактерии: купаться в них опасно
Onliner.by
11 июля 2024 г.
3 мин чтения
948 просмотров
Ребенок, играющий в жаркий день в городском фонтане, — это обычная летняя картина. Однако, согласно мнению экспертов, такие заплывы могут иметь серьезные последствия.
Вода в фонтанах не обрабатывается так же, как в бассейнах, и она не пригодна для питья или купания. Это может привести к острой кишечной инфекции, конъюнктивиту и даже вирусному гепатиту А.
Чтобы подтвердить это, сотрудники Могилевского зонального центра гигиены и эпидемиологии в начале июля взяли пробы воды из трех популярных городских фонтанов. Результаты были впечатляющими: во всех образцах обнаружили колонии кишечной палочки (в одном из фонтанов содержание этой бактерии превысило норму в 6 раз), а в двух других фонтанах вода была настолько загрязнена, что даже ополаскивать руки и вытирать лицо в ней было небезопасно.
Вода в фонтанах не обрабатывается так же, как в бассейнах, и она не пригодна для питья или купания. Это может привести к острой кишечной инфекции, конъюнктивиту и даже вирусному гепатиту А.
Чтобы подтвердить это, сотрудники Могилевского зонального центра гигиены и эпидемиологии в начале июля взяли пробы воды из трех популярных городских фонтанов. Результаты были впечатляющими: во всех образцах обнаружили колонии кишечной палочки (в одном из фонтанов содержание этой бактерии превысило норму в 6 раз), а в двух других фонтанах вода была настолько загрязнена, что даже ополаскивать руки и вытирать лицо в ней было небезопасно.
На фотографиях видно, как выглядят эти опасные бактерии.

Важно помнить, что вода в фонтанах не проходит обеззараживание и редко обновляется. Поэтому, несмотря на жару, лучше воздержаться от купания в них и выбирать более безопасные места для охлаждения.
Следите за нами в Instagram, подписывайтесь на наш Telegram-канал!
Подпишись на нас в Telegram
ПодписатьсяПодпишись на нас в Instagram
Подписаться📌 Полезное по теме
Комментарии
Поделитесь своим мнением. Новые комментарии появляются после модерации.
Написать комментарий
Отправляя комментарий вы соглашаетесь с публикацией и нашей политикой модерации. Мы скрываем личные данные и удаляем спам.
